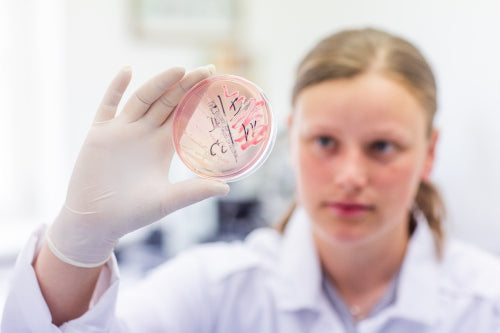

Unsere Leistungen

Testkits für Kleinsäuger
Unsere speziell entwickelten Untersuchungssets für Kaninchen, Meerschweinchen, Ratten und andere Kleinsäuger helfen dir dabei, den Gesundheitszustand deiner Tiere frühzeitig zu überprüfen. Ob Parasiten, Giardien oder bakterielle Belastungen – mit unseren Laborkits erhältst du klare, schnelle Diagnosen, ganz ohne Tierarztbesuch.
Zu den Kleinsäuger Testkits
Testkits für Fleischfresser
Gesundheit beginnt im Darm! Unsere Fleischfresser-Profile sind optimal für Hunde und Katzen geeignet, um Parasiten, Giardien und sogar Lungenwürmer frühzeitig zu erkennen. Die Laboranalyse liefert zuverlässige Ergebnisse – bequem von zu Hause aus.
Zu den Fleischfresser Testkits
Über uns
Seit dem Jahr 2000 bietet exomed seine Dienstleistungen als veterinärmedizinisches Exotenlabor an. Unser Kundenkreis umfasst TierärztInnen, HerpetologInnen, ZüchterInnen sowie eine Vielzahl von PrivathalterInnen. Darüber hinaus zählen auch zoologische Gärten und wissenschaftliche Einrichtungen zu unseren regelmäßigen Einsendern.
Wir haben uns auf zwei Hauptbereiche spezialisiert: Die gezielte Diagnostik zur Parasitenbekämpfung bei Heimtieren wie Reptilien, Amphibien, Fischen, Kaninchen, Degus, Chinchillas und anderen Arten sowie den Nachweis von Würmern und anderen Parasiten bei Nutztieren, Hunden, Katzen und weiteren Tierarten.

Unser umfangreiches Leistungsspektrum umfasst auch die Mikrobiologie, einschließlich Bakterien, Pilze, Umweltkeime und Darmflora. Darüber hinaus bieten wir Sektionen an. Bei all unseren Tätigkeiten halten wir uns an die neuesten wissenschaftlichen Standards und pflegen einen engen Austausch mit TierärztInnen, ZüchterInnen, Universitäten, Forschungseinrichtungen im In- und Ausland sowie Partnerlaboren.
Ein weiterer wichtiger Bereich unserer Arbeit liegt in der Forschung zu Parasitosen bei Kaltblütern wie Reptilien und Amphibien. Im Laufe der letzten Jahre sind zahlreiche wissenschaftliche Arbeiten in unserem Labor entstanden, die zu diesem Thema veröffentlicht wurden.
Weitere Informationen












